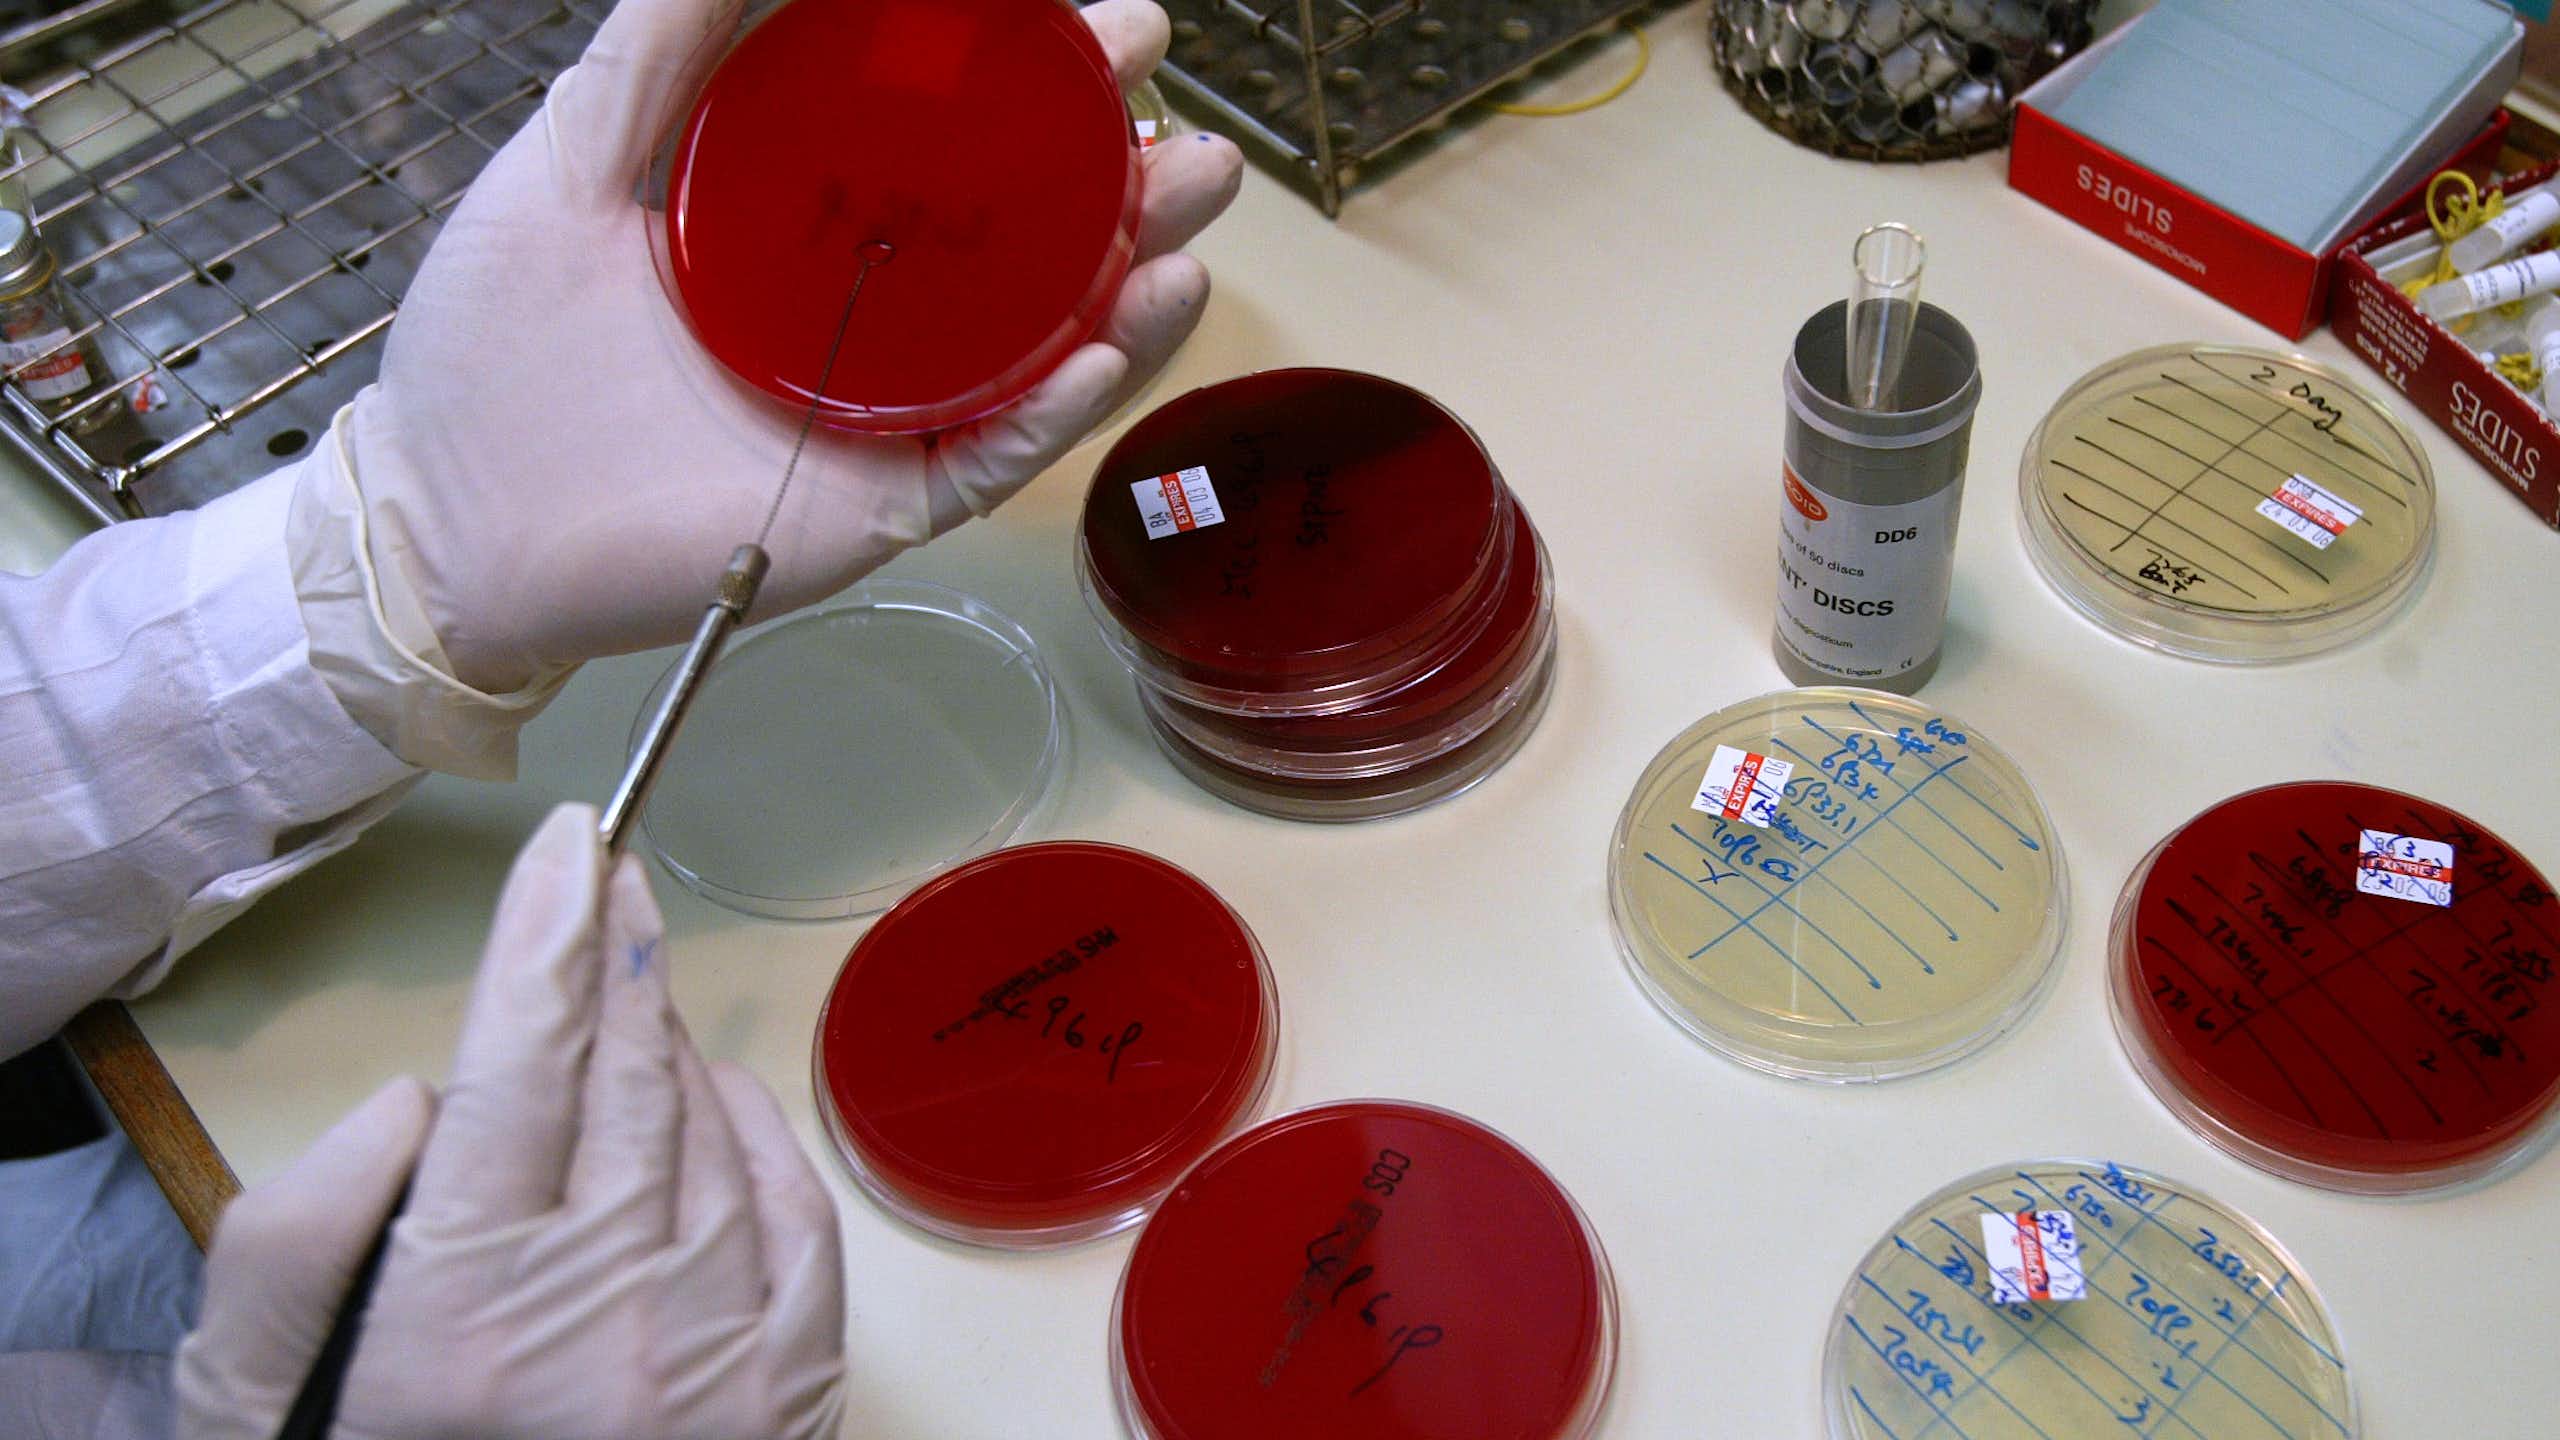
Gloved hands and round glass dishes in a laboratory environment
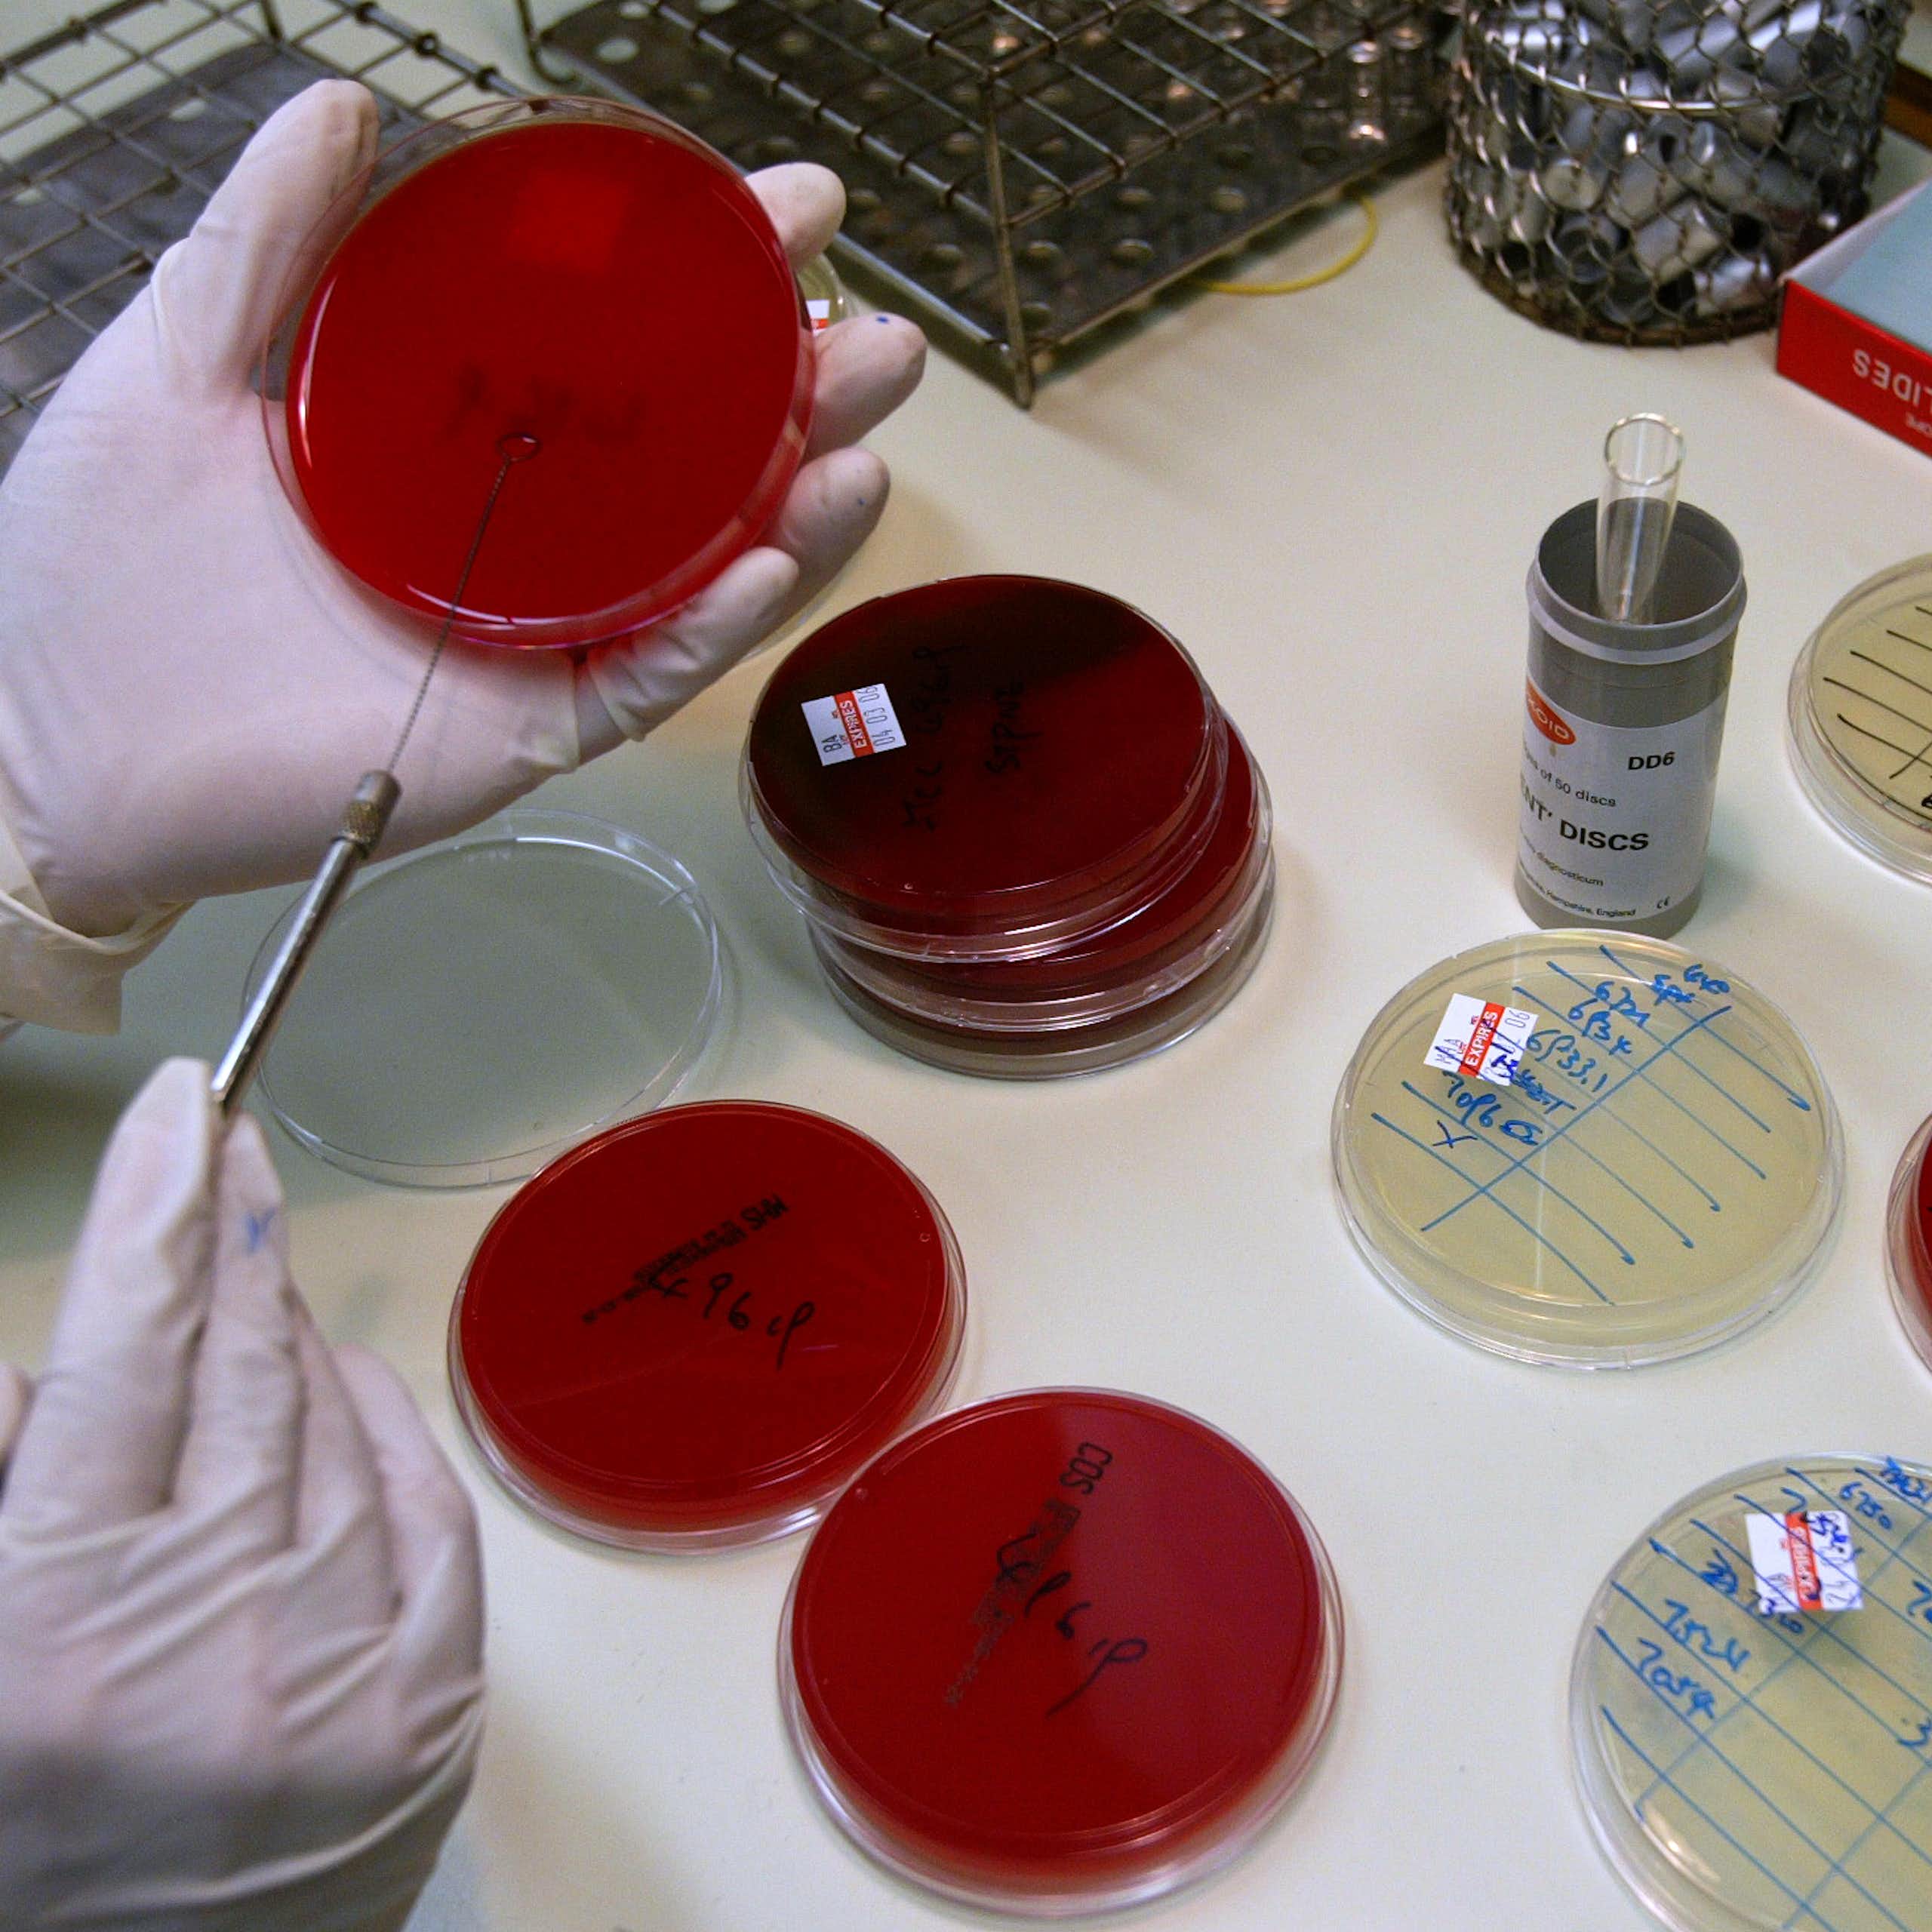
Gloved hands and round glass dishes in a laboratory environment
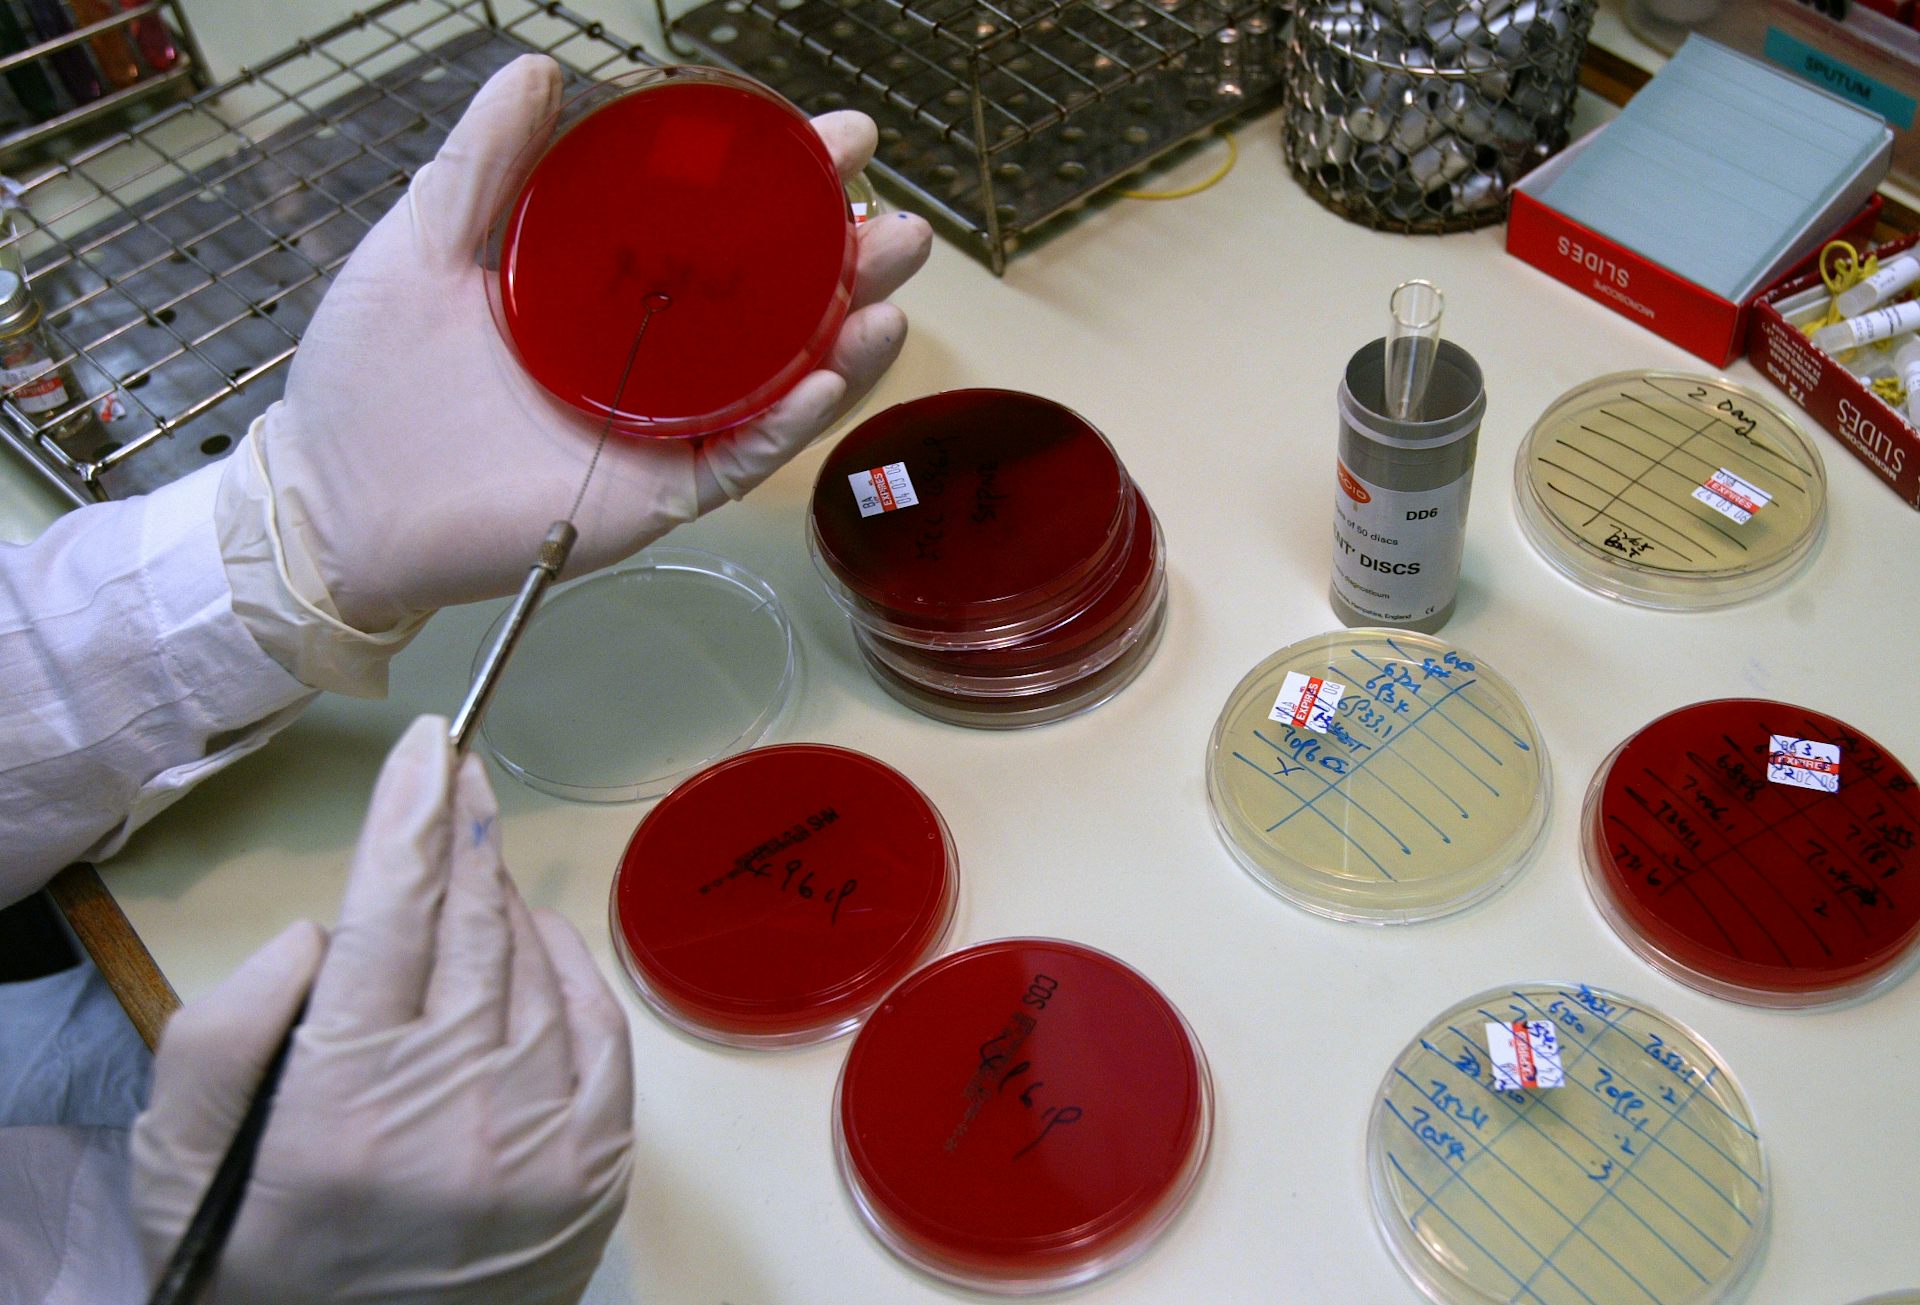
Gloved hands and round glass dishes in a laboratory environment

Get evidence-based news in your inbox, for free
Subscribe to our daily newsletterG20
In the news
What's trending
Development finance
Are you captivated by our content?
Click here to let us know in a short surveyMovies, Music & Reviews
Got a great idea for an article?
Pitch it to us hereResearch highlights
You might also like...
Get daily updates from The Conversation Africa
Follow our WhatsApp channelMost read this week
TC Afrique
Facts power The Conversation Africa. You can too.
Support our cause. Donate today.Our Partners
The Conversation is funded by its member institutions, sector funding partners and the generosity of our readers. Our huge thanks to our founding partners, our members and all those supporting organisations in our network.
View all our partners